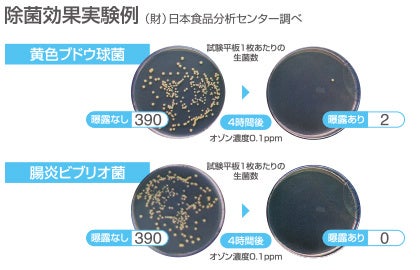

【リニューアル】オゾン発生器ゲルリッツが軽く小さくパワフルに!除菌・脱臭
感染対策や染みついてしまった残存臭も解決!病院、救急車、ホテル、会議室などにも
株式会社カルモア(本社:東京都中央区)が、オゾン発生器Goerlitz-R(旧型)の「最新作G-zero( 新型 )」をリリース。従来機に比べ半分の重さに軽量化し、オゾン発生量は3倍以上に増量いたしました。
■ゲルリッツ(【新型】G-zero)オゾン発生器
当社オゾン発生器「Goerlitz-R」→「G-zero( 新型 )」にリニューアルしたことで持ち運びが便利になり、女性でも軽々と持ち運べる重さに!従業員の方々の負担にならない重量まで軽量化しました。
またG-zeroになることで60分までのタイマーが180分までと延長。長時間タイマーがついているので、大空間も放置しているだけで自動的に除菌脱臭してくれ、連続運転機能もあるので頑固なニオイも脱臭しやすくなりました。
さらに作業終了後はオゾンを回収する機能がついているので、換気のできない部屋でも使用することができ、オゾンが発生している部屋に入る必要もありません。
G-zeroは「軽さ・パワー・タイマー」といった機能面だけでなく、人体への影響まで配慮しているので安全性に不安を持たれている法人様にも、ご利用頂いております。
・販売ページリンク:https://www.goerlitz.jp/lp2020/?utm_source=karumoa_main&utm_medium=banner&utm_campaign=01
■オゾン発生器とは
□1:除菌だけでなく脱臭まで可能。
オゾンは雑菌の除菌だけでなく、ニオイ成分の脱臭まですることが可能です。
ゲルリッツ(【新型】G-zero)は、その力をいかし簡単に清潔で安全な空間を作り出せる機器です。
□2:オゾンって何?オゾンは酸素の原子が3つ繋がった同素体です。
・強力な酸化力
オゾンは塩素よりも、約6倍ほど酸化力がある特徴を持っています。
酸化力が強いため、菌を酸化させることで除菌・ニオイの分解まで効果を発揮します。
・原料は空気
オゾンの素材(原料)となるのは空気中に漂う酸素なので、電源さえあれば利用できてコストが安い特徴があります。
・残存性がない
オゾンは一定時間すると酸素に戻るため残存性がなく、除菌・脱臭による反応で消費されるので安心してご利用頂けます。
□3:オゾンの脱臭
オゾン脱臭は芳香剤や消臭剤と違いニオイの元から分解するので、染みついた臭いにも効果的です。
また、オゾンは多くの臭気成分と反応しやすい特性があり、有機物・無機物に関わらず脱臭効果を発揮してくれます。
□4:除菌にもオゾンが有効
一般的に薬剤の除菌では細菌やウイルスの核に作用するのですが、 それでは耐性菌ができてしまう可能性があります。
□5:除菌効果実験例
オゾン発生器をショーケース(約 10°C)に設置し、黄色ブドウ球菌と腸炎ビブリオ菌の菌液を塗布した試験平板を入れてオゾンに曝露させた結果。4時間後の試験平板上の細菌数が大きく減少する事を確認出来ました。
・オゾン発生器についての詳しい解説:https://www.karumoa.co.jp/column/basic/ozone/
■ゲルリッツ(【新型】G-zero)の使い方
□STEP1
コンセントを入れて本体正面の右にある、電源スイッチをオンにして起動します。
□STEP2
つまみを回して指定したい時間に合わせてタイマーをセットします。
□STEP3
安全のため数十秒アイドリングを行います。(運転が開始した後は速やかに部屋から退出して下さい。)
□STEP4
設定した時間になると自動的に運転がとまり、オゾンの回収が始まります。
□STEP5
オゾンが確認されたことを確認したら、電源を止めてください。
と操作がシンプルで覚えやすいので、誰でも簡単に取り扱うことができます。
■オゾン発生器がよく利用される施設
<カルモア公式サイト>
公式サイト:https://www.karumoa.co.jp/

当社オゾン発生器「Goerlitz-R」→「G-zero( 新型 )」にリニューアルしたことで持ち運びが便利になり、女性でも軽々と持ち運べる重さに!従業員の方々の負担にならない重量まで軽量化しました。


またG-zeroになることで60分までのタイマーが180分までと延長。長時間タイマーがついているので、大空間も放置しているだけで自動的に除菌脱臭してくれ、連続運転機能もあるので頑固なニオイも脱臭しやすくなりました。
さらに作業終了後はオゾンを回収する機能がついているので、換気のできない部屋でも使用することができ、オゾンが発生している部屋に入る必要もありません。
G-zeroは「軽さ・パワー・タイマー」といった機能面だけでなく、人体への影響まで配慮しているので安全性に不安を持たれている法人様にも、ご利用頂いております。
・販売ページリンク:https://www.goerlitz.jp/lp2020/?utm_source=karumoa_main&utm_medium=banner&utm_campaign=01
■オゾン発生器とは
□1:除菌だけでなく脱臭まで可能。
オゾンは雑菌の除菌だけでなく、ニオイ成分の脱臭まですることが可能です。
ゲルリッツ(【新型】G-zero)は、その力をいかし簡単に清潔で安全な空間を作り出せる機器です。
□2:オゾンって何?オゾンは酸素の原子が3つ繋がった同素体です。

・強力な酸化力
オゾンは塩素よりも、約6倍ほど酸化力がある特徴を持っています。
酸化力が強いため、菌を酸化させることで除菌・ニオイの分解まで効果を発揮します。
・原料は空気
オゾンの素材(原料)となるのは空気中に漂う酸素なので、電源さえあれば利用できてコストが安い特徴があります。
・残存性がない
オゾンは一定時間すると酸素に戻るため残存性がなく、除菌・脱臭による反応で消費されるので安心してご利用頂けます。
□3:オゾンの脱臭

オゾン脱臭は芳香剤や消臭剤と違いニオイの元から分解するので、染みついた臭いにも効果的です。
また、オゾンは多くの臭気成分と反応しやすい特性があり、有機物・無機物に関わらず脱臭効果を発揮してくれます。
□4:除菌にもオゾンが有効

一般的に薬剤の除菌では細菌やウイルスの核に作用するのですが、 それでは耐性菌ができてしまう可能性があります。
□5:除菌効果実験例
オゾン発生器をショーケース(約 10°C)に設置し、黄色ブドウ球菌と腸炎ビブリオ菌の菌液を塗布した試験平板を入れてオゾンに曝露させた結果。4時間後の試験平板上の細菌数が大きく減少する事を確認出来ました。
・オゾン発生器についての詳しい解説:https://www.karumoa.co.jp/column/basic/ozone/
■ゲルリッツ(【新型】G-zero)の使い方

□STEP1
コンセントを入れて本体正面の右にある、電源スイッチをオンにして起動します。
□STEP2
つまみを回して指定したい時間に合わせてタイマーをセットします。
□STEP3
安全のため数十秒アイドリングを行います。(運転が開始した後は速やかに部屋から退出して下さい。)
□STEP4
設定した時間になると自動的に運転がとまり、オゾンの回収が始まります。
□STEP5
オゾンが確認されたことを確認したら、電源を止めてください。
と操作がシンプルで覚えやすいので、誰でも簡単に取り扱うことができます。
■オゾン発生器がよく利用される施設

<カルモア公式サイト>
公式サイト:https://www.karumoa.co.jp/
このプレスリリースには、メディア関係者向けの情報があります
メディアユーザーログイン既に登録済みの方はこちら
メディアユーザー登録を行うと、企業担当者の連絡先や、イベント・記者会見の情報など様々な特記情報を閲覧できます。※内容はプレスリリースにより異なります。
すべての画像
